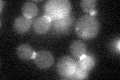
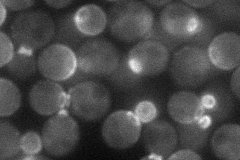
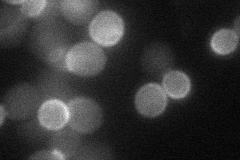
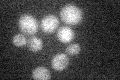

View description
Putative GTPase-activating protein (GAP) involved in the Pkc1p-mediated signaling pathway that controls cell wall integrity; appears to specifically regulate 1,3-beta-glucan synthesis
Localization:
Intensity:
Fold change:
Significance:
-
C’ GFP library in SD
bud neckN/A -
N' NOP1pr-GFP in SD
bud,bud neck36.979 -
N' TEF2pr-mCherry in SD
cytosol29.1852 -
N' NATIVEpr-GFP in SD

bud neck22.3704 -
N' TEF2pr-VC and Cyto-VN in SD

bud neck28.0349 -
C’ GFP library in SD+DTT

bud neck21.190.96No -
C’ GFP library in SD+H2O2

bud neck26.611.2No -
C’ GFP library in Starvation Media
cytosol23.161.05No -
C’ GFP library on the background of Pup2-DaMP

bud neck -
C’ GFP library on the background of CCT mutant

bud neck24.71581.12276No
